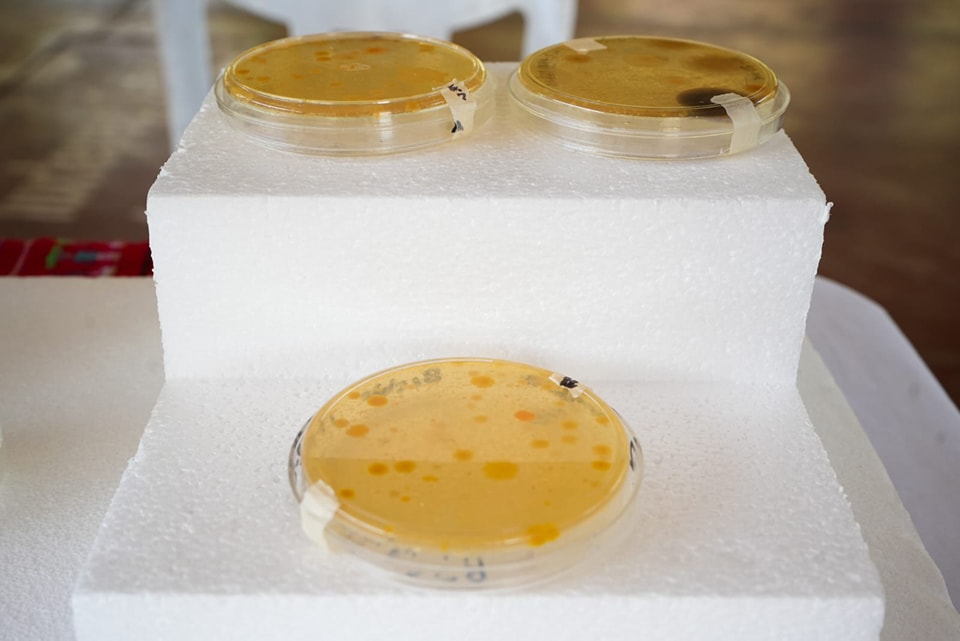

En el marco del Día Mundial del Agua, el Gobierno Municipal de Tuxtepec junto con la Universidad Del Papaloapan (UNPA) Campus Tuxtepec, llevaron a cabo un ciclo de conferencias dirigidas a los alumnos, abordando temas sobre la contaminación y escasez del agua.